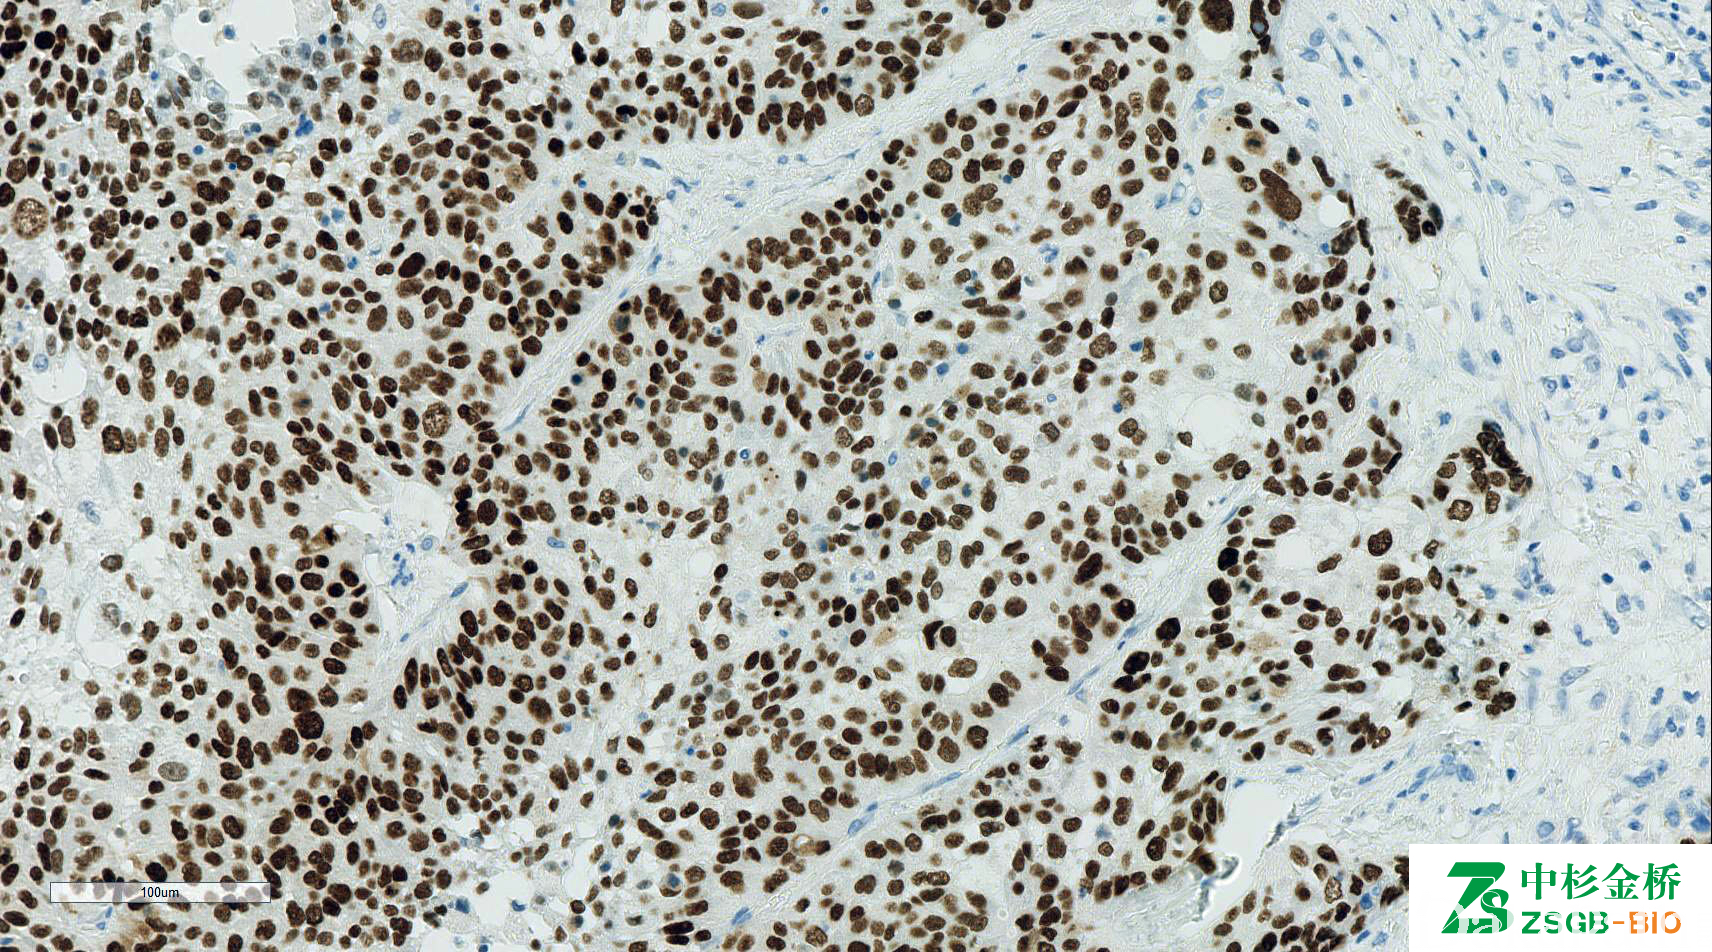

P63

别名: 63PO2;7JUL;H-137;4A4;BC4A4
概述:
P53 家族成员,标记多种上皮的基底细胞,胸腺瘤中的上皮样成分 (+),标记肌上皮及其肿瘤。表达于鳞状上皮及尿路上皮的基底层和乳腺、前列腺、涎腺基底细胞。
信号定位: 胞核
在病理学中的应用:
- 肺腺癌与鳞癌(+)的鉴别诊断;
- 乳腺、涎腺、前列腺浸润性癌与非浸润性癌的鉴别诊断;
- 汗腺癌与转移性乳腺癌的鉴别诊断;
- 与 PAX8 联用用于肾集合管癌与尿路上皮癌的鉴别诊断。
商品化试剂(排名不分先后,本网站对抗体质量不负责!)
公司 | 克隆号 | 即用型(ml) | 原液(ml) | ||||
基因科技 | 4A4 | 1 | 2 | 4 | 7 | 0.2 | 1 |
中杉金桥 | 4A4 | 1.5 | 3 | 6 | / | 0.1 | 0.2 |
安必平 | 2B10 | 1.5 | 3 | 6 | / | 0.1 | 0.2 |
4A4 | |||||||
福建迈新 | MX013 | 1.5 | 3 | 6 | / | / | 0.2 |
4A4 | 1.5 | 3 | 6 | / | / | 0.2 | |
在肿瘤中的表达情况:
几乎全部阳性(≥95%的病例阳性): 喉鳞状细胞癌、微囊性附属器癌、皮肤鳞状细胞癌、皮脂腺腺癌、皮脂腺腺瘤、宫颈鳞状细胞癌、非浸润性乳头状尿路上皮癌,低级别、皮肤基底细胞癌、膀胱原位尿路上皮癌、食管鳞状细胞癌、良性胸腺瘤、淋巴上皮癌、涎腺导管腺癌、乳腺胶原小体病、甲状腺癌显示胸腺样分化、基底细胞腺瘤、黏液表皮样癌、肺鳞状细胞癌、汗管瘤、毛发上皮瘤、阴道鳞状细胞癌、小汗腺汗孔瘤、胎盘部位结节、小汗腺螺旋腺瘤、大汗腺腺瘤、外阴鳞状细胞癌、肺细胞腺肌上皮瘤,肌上皮成分、阴茎肉瘤样癌、皮脂腺上皮肌上皮癌、涎腺印戒细胞癌、套细胞淋巴瘤、上皮肌上皮癌,肌上皮成分、胰腺腺鳞癌、耳鼻喉非角化性鳞状细胞癌、恶性毛根鞘瘤、汗腺透明细胞腺癌、膀胱鳞状细胞癌、小汗腺汗孔癌、前列腺基底细胞增生、内翻性乳头状瘤、涎腺腺淋巴瘤、毛母质瘤、乳腺小叶原位癌、肛管鳞状细胞癌、肛管鳞状细胞癌、前列腺高级别上皮内瘤变、上皮样滋养层细胞肿瘤、外毛根鞘瘤、直肠鳞状细胞癌、阴经鳞状细胞癌、尿路上皮癌、肺黏液表皮样癌、肛门小细胞癌、宫颈乳头状鳞状细胞癌、宫颈梭形细胞鳞状细胞癌、多形性腺瘤、大汗腺上皮肌上皮癌,肌上皮成分、角化棘皮瘤、皮肤小汗腺乳头状腺瘤、皮脂腺癌,上皮肌上皮,肌上皮成分、前列腺腺体萎缩、青少年乳腺乳头状瘤病、乳腺导管增生
通常阳性(<95%,≥75%的病例阳性): 弥漫大 B 型大 B 细胞淋巴瘤,非特指型、膀胱尿路上皮癌、前列腺腺样囊腺癌,基底细胞、涎腺母细胞瘤、肺 NUT 癌、胸腺基底细胞样癌、腺样囊性癌、耵聍腺腺瘤、耳鼻喉鳞状细胞癌、乳腺腺样囊性癌、骨巨细胞瘤、肺贴壁型腺癌,黏液非黏液混合性、软骨样汗腺腺瘤、鲍温病、基底样鳞状细胞癌、皮肤小汗腺腺癌、肺腺鳞癌、巢状尿路上皮癌、乳腺囊性高分泌型导管内乳头状癌、乳腺包裹性乳头状癌、甲状腺鳞状细胞癌、纵膈大 B 细胞淋巴瘤、汗腺癌、汗腺囊瘤、乳腺导管内乳头状瘤
经常阳性(<75%,≥55%的病例阳性): 细胞性神经鞘黏液瘤、弥漫大 B 细胞淋巴瘤,生发中心细胞来源、乳腺化生性癌、非浸润性乳头状尿路上皮癌,高级别、子宫内膜绒毛膜癌、乳腺导管原位癌、甲状腺乳头状癌、膀胱肉瘤样尿路上皮癌、乳腺基底样导管内癌、肺贴壁型腺癌、膀胱透明细胞癌、膀胱腺癌,非特指型、弥漫大 B 细胞淋巴瘤,非生发中心来源、皮肤合体细胞性肌上皮瘤、皮肤 Merkel 细胞癌、耳鼻喉梭形细胞癌、涎腺小管腺瘤、尿路淋巴上皮瘤样癌、肺非典型腺瘤样增生、鲍温样丘疹病
有时阳性(<55%,≥35%的病例阳性): 肌上皮癌、中间型滋养细胞肿瘤、耵聍腺癌、肺大细胞癌、肺肉瘤样癌、耳鼻喉神经内分泌癌、软骨母细胞瘤,NOS、淋巴瘤样或浆细胞样尿路上皮癌
少数阳性(<35%,≥15%的病例阳性): 肌上皮瘤、子宫内膜间质肿瘤、甲状腺结节性增生、原始神经外胚层瘤、鼻窦未分化癌、尤文肉瘤、神经束膜瘤、涎腺腺泡细胞癌、乳腺恶性叶状肿瘤、胆管癌、子宫内膜腺癌、结外 NK/T 细胞淋巴瘤,鼻型、鼻窦腺癌,NOS、甲状腺滤泡型乳头状癌、宫颈腺癌,非特指型、大细胞神经内分泌癌、乳腺基底样癌,三阴性、胃腺癌、乳腺叶状肿瘤,梭形细胞成分、动脉瘤样骨囊肿、肺腺癌
偶尔阳性(<15%,≥5%的病例阳性): 上皮样间皮瘤、未分化多形性肉瘤、肝细胞癌、恶性外周神经鞘膜瘤、肾细胞癌、促结缔组织增生性黑色素瘤、去分化脂肪肉瘤、结直肠神经内分泌癌、促结缔组织增生性小圆细胞肿瘤、骨外黏液性软骨肉瘤、低级别纤维黏液肉瘤、黏液纤维肉瘤、腱鞘巨细胞瘤、乳腺癌,腔型、嗅神经母细胞瘤、皮肤大汗腺腺癌、乳腺伴大汗腺分化的癌、滑膜肉瘤、上皮样肉瘤、胚胎性横纹肌肉瘤、肾源性腺瘤、胰腺导管腺癌
几乎全部阴性(<5%的病例阳性): 黏液性/圆细胞脂肪肉瘤、胰腺上皮内肿瘤、结直肠腺癌、恶性黑色素瘤、横纹肌肉瘤,NOS、纤维肉瘤、隆突性皮肤纤维肉瘤、平滑肌肉瘤,NOS、神经鞘膜瘤,NOS、前列腺腺泡性癌、间皮瘤,NOS、上皮样血管内皮瘤、子宫内膜间质肉瘤、非典型纤维黄色瘤、甲状腺滤泡性腺瘤、颗粒细胞瘤、淋巴细胞性甲状腺炎(乔本甲状腺炎)、甲状腺滤泡性癌、软骨肉瘤、恶性神经鞘瘤、滤泡树突状细胞肿瘤、乳腺分泌性癌、腺泡状软组织肉瘤、经典型霍奇金淋巴瘤、非典型性脂肪瘤性肿瘤、上皮样多形性脂肪肉瘤、胃肠道间质瘤、涎腺嗜酸细胞瘤、黏液恶性纤维组织细胞瘤、腺泡状横纹肌肉瘤、血管球瘤、Kaposi 肉瘤、神经纤维瘤、乳腺黏液癌、纤维瘤病、炎性假瘤、血管肉瘤、透明细胞肉瘤、血管肌脂肪瘤、乳腺交界性叶状肿瘤、深部韧带样纤维瘤病、胚胎性癌、垂体腺瘤、垂体腺瘤,促性腺激素阳性、垂体腺瘤,分泌促甲状腺激素、垂体腺瘤,分泌促肾上腺皮质激素、垂体腺瘤,分泌卵泡刺激素、垂体腺瘤,分泌泌乳素、垂体腺瘤,分泌生长激素、垂体腺瘤,裸细胞、乳腺良性叶状肿瘤、结节性筋膜炎、胎盘部位超常反应、胎盘部位滋养细胞肿瘤、血管瘤样恶性纤维组织细胞瘤、食管腺癌、恶性腱鞘巨细胞瘤、良性纤维组织细胞瘤、皮肤纤维肉瘤、涎腺类似于乳腺的分泌性癌、肺细胞腺肌上皮瘤,上皮成分、皮肤黏液癌、纤维结构不良、鼻窦腺癌,非肠型、肌纤维母细胞瘤、上皮肌上皮癌,上皮成分、乳腺筛状癌、黏液瘤,NOS、胆道腺瘤、乳腺外 Paget 病、乳腺 Paget 病、乳腺小管癌、乳腺浸润性癌,非特殊类型、甲状腺腺瘤、乳腺乳头状癌、软骨黏液样纤维瘤、黏液性脂肪肉瘤、脐尿管黏液性囊腺瘤、脐尿管低度恶性潜能未定的黏液性囊性肿瘤、脂肪母细胞瘤、梭形细胞脂肪瘤、软组织骨化性纤维黏液样肿瘤、前列腺癌,≥gleason8 分、乳腺浸润性小叶癌、胆管非典型增生、平滑肌瘤、乳腺髓样癌、大汗腺上皮肌上皮癌,上皮成分、皮脂腺癌,上皮肌上皮,上皮成分
